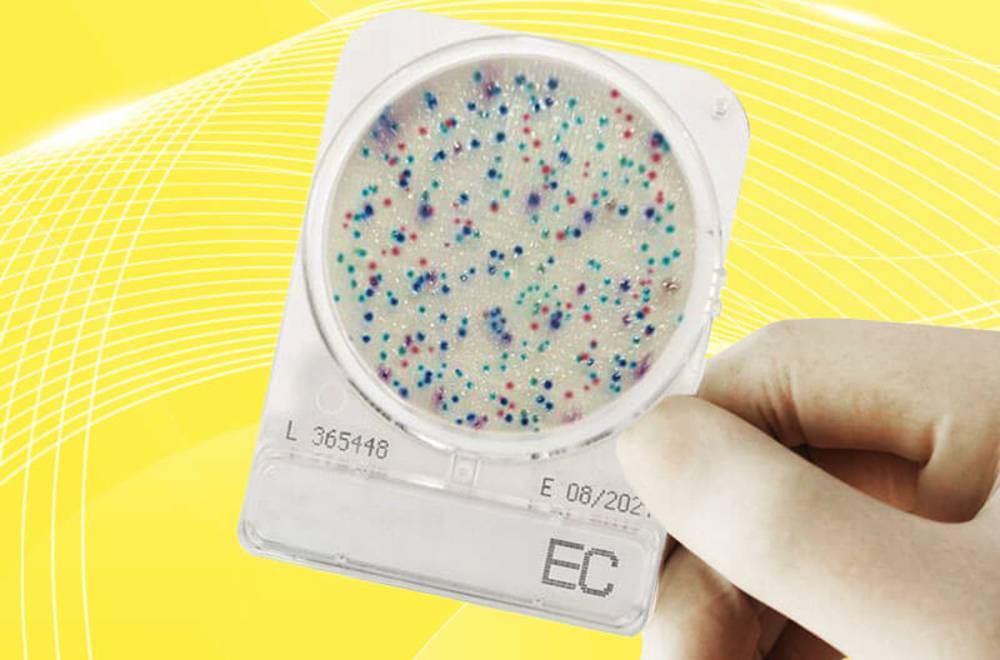
Compact Dry – найсучасніший мікробіологічний контроль (відео)

-
Зернові культури
- Процеси, необхідні для дослідження зернових культур
-
Показники якості зерна
- Засміченість, зараженість шкідниками
- Натура
- Склоподібність
-
Вологість
- Сушильні шафи для зерна
- Аналізатори вологості зерна
- Вологоміри зерна
-
ІЧ-аналізатори для контролю рівня вологості в зерні
- Інфрачервоні аналізатори цільного зерна AgriCheck для контролю рівня вологи
- ІЧ-аналізатор зерна, кормів та харчових продуктів SpectraStar XT Unity Scientific
- Портативний ІЧ-аналізатор цільного зерна IAS 3120, Intelligent Analysis Service для контролю рівня вологості
- ІЧ аналізатор QuikCheck
- Потокові аналізатори зерна для виробничих ліній
- Портативний ІЧ-аналізатор SCIO Cup
-
Білок
-
ІЧ-аналізатори
- Портативний ІЧ-аналізатор цільного зерна IAS 3120, Intelligent Analysis Service для контролю рівня білка
- Інфрачервоні аналізатори цільного зерна AgriCheck для контролю рівня білка
- Потокові аналізатори для виробничих ліній
- ІЧ-аналізатор зерна, кормів та харчових продуктів SpectraStar XT Unity Scientific
- Портативний ІЧ-аналізатор SCIO Cup
- Визначення білка в зерні методом К’єльдаля
- Визначення білка методом Дюма
-
ІЧ-аналізатори
- Олійність
- Клітковина
- Зольність
-
Клейковина
- Система для визначення кількості і якості клейковини в зерні механічним методом
- Набір для визначення кількості і якості клейковини ручним методом
-
ІЧ-аналізатори
- Портативний ІЧ-аналізатор цільного зерна IAS 3120, Intelligent Analysis Service для контролю якості клейковини
- Інфрачервоні аналізатори цільного зерна AgriCheck для контролю рівня клейковини
- ІЧ-аналізатор зерна, кормів та харчових продуктів SpectraStar XT Unity Scientific
- Портативний ІЧ-аналізатор SCIO Cup
- Число падіння
- Мікотоксини
- ГМО
- Сажка
- Радіонукліди
- Токсичні елементи
- Пестициди
-
Олійні культури
- Процеси
-
Показники якості олійних культур
- Сміттєва і олійна домішка, зараженість
- Натура
-
Вологість
- Сушильні шафи
- Аналізатори вологості
- Вологоміри зерна
-
ІЧ-аналізатори
- Інфрачервоні аналізатори цільного зерна AgriCheck для контролю рівня вологості в олійних культурах
- Портативний ІЧ-аналізатор цільного зерна IAS 3120, Intelligent Analysis Service для контролю рівня вологості в олійних культурах
- ІЧ аналізатор QuikCheck
- Потокові аналізатори для виробничих ліній
- ІЧ-аналізатор зерна, кормів та харчових продуктів SpectraStar XT Unity Scientific
- Портативний ІЧ-аналізатор SCIO Cup
-
Білок
-
ІЧ-аналізатори
- Портативний ІЧ-аналізатор SCIO Cup
- Інфрачервоні аналізатори цільного зерна AgriCheck
- Портативний ІЧ-аналізатор цільного зерна IAS 3120, Intelligent Analysis Service для контролю рівня білка в олійних культурах
- Потокові аналізатори для виробничих ліній
- ІЧ-аналізатор зерна, кормів та харчових продуктів SpectraStar XT Unity Scientific
- Визначення білка методом К’єльдаля
- Визначення білка методом Дюма
-
ІЧ-аналізатори
-
Жир (олійність)
- Визначення жиру методом імпульсної ЯМР-спектроскопії
- Визначення жиру методом екстракції
-
ІЧ-аналізатори
- Портативний ІЧ-аналізатор SCIO Cup
- Інфрачервоні аналізатори цільного зерна AgriCheck для контролю рівня жиру в олійних культурах
- Портативний ІЧ-аналізатор цільного зерна IAS 3120, Intelligent Analysis Service для контролю рівня жиру в олійних культурах
- ІЧ-аналізатор зерна, кормів та харчових продуктів SpectraStar XT Unity Scientific
- Кислотне число, кислотність
- Олеїнова кислота
- ГМО
- Мікотоксини
- Радіонукліди
- Токсичні елементи
- Пестициди
- Глюкозинолати
-
Комбікорм
- Процеси
-
Показники якості комбікормів
- Вологість
- Білок
- Жир (олійність)
- Клітковина
- Крохмаль
- Зольність
- Фосфор
- Кислотність, кальцій і вміст солі (NaCl)
- Активність уреази
- Загальна токсичність кормів
- Крихкість гранул
- Міцність гранул
- Радіонукліди
- Пестициди
- Амінокислотний аналіз комбікормів
- Мікотоксини
- Вітаміни
- Важкі метали
-
Олії та жири
- Процеси, необхідні для дослідження олії і жирів
-
Показники якості рослинної олії
- Жир (шрот, макуха)
- Білок (шрот, макуха)
- Клітковина (шрот, макуха)
- Кислотне число
- Перекисне число
- Анізидинове число
- Олеїнова кислота
- Фосфоровмісні речовини (фосфоліпіди)
- Колірність
- Йодне число
- Вологість
- В'язкість олії
- Температура спалаху
- Жирнокислотний склад
- Окислювальна стабільність
- Контроль гігієни поверхонь та рідин
-
Насіння
- Процеси
- Показники якості насіння
-
Ґрунт
-
Процеси, необхідні для дослідження ґрунту
- Пробовідбір
- Зважування
- Сушіння
- Подрібнення
- Виділення фракції
- Підготовка води
- Приготування витяжки
- Миття та дезінфекція
-
Показники якості ґрунту
- Кислотність витяжки ґрунту
- Загальний солевміст та електропровідність
- Активність іонів
- Азот (нітратна та амонійна форми)
- Фосфор
- Азот лужногідролізований (за Корнфілдом)
- Азот
- Калій
- Кальцій та магній (обмінні)
- Гранулометричний склад
- Вуглець
- Органічна речовина (гумус) у ґрунті
- Мікроскопічне дослідження ґрунту
- Елементний склад і забруднення металами
- Стійкі органічні забруднювачі
- Радіонукліди
- Нафтопродукти
- Експрес-аналіз ґрунту в полі
-
Процеси, необхідні для дослідження ґрунту
-
Молоко
- Процеси, необхідні для дослідження молока
-
Показники якості молока
- Масова частка сухих речовин у молоці
- Густина молока
- Кислотність молока
- Чистота молока
- Точка замерзання молока
- Масова частка жиру в молоці
- Масова частка білку в молоці
- Вміст лактози
- Мікробіологічні показники
- Кількість соматичних клітин
- Наявність речовин, які подовжують терміни зберігання молока
- Залишки антибіотиків
- Вміст сечовини
- Вміст афлатоксину М1
- Токсичні елементи (важкі метали)
- Вміст пестицидів
- Фальсифікати
- Визначення ефективності пастеризації
- Визначення рівня термообробки
- Термостійкість молока
-
Молочні продукти
- Процеси, необхідні для дослідження молочних продуктів
-
Показники якості молочних продуктів
- Алергени
- Жир
- Білок
- Чистота
- Насипна щільність
- Розміри кристалів цукру
- Зола
- В’язкість
- Кухонна сіль
- Кислотність
- Вільні жирні кислоти
- Волога й сухі речовини
- Перекисне число жиру
- Лактоза
- Густина
- Цукор
- Бензойна й сорбінова кислоти
- Натаміцин (Е325)
- Жирно-кислотний склад
- Лужна фосфатаза
- Стеринова фракція та тригліцериди
-
Борошно
- Процеси, необхідні для дослідження борошна
-
Показники якості борошна
- Зараженість шкідниками, забрудненість і металодомішки
- Крупність
- Вологість
- Білок
- Клейковина
- Білизна (колір борошна)
- Зольність
- Число падіння
- Кислотність
- Мікотоксини
- Радіонукліди
- Токсичні елементи
- Пестициди
- Мед
- М'ясо та м'ясні продукти
- Мікробіологія
-
Безалкогольні напої
-
Основні показники якості
- Титрована і загальна кислотність
- рН (активна кислотність)
- Сухі речовини
- Властивості напоїв
- Цукри та підсолоджувачі
- Гідроксиметилфурфурол
- Вітаміни
- Мікотоксини
- Органічні речовини в напоях
- Комплексні показники питної та мінеральної води
- Визначення герметичності закупорювання
- Експрес-аналіз на виробництві
- Стійкість
- Каламутність
- Пектинові речовини
- Спирт
- Концентрація СО2
- Колір
-
Основні показники якості
Compact Dry – найсучасніший мікробіологічний контроль (відео)
Під час аналізу суспензія досліджуваного зразка, об’ємом 1 мл, наноситься на чашку та дифузійно розподіляється по її поверхні. Результати визначають після культивування за кількістю контрастних колоній, які виросли на поверхні середовища. Для зручності підрахунку на дно чашки нанесено сітку. Для отримання змивів є зручні сваби з буферним розчином.
Пропонуємо нове відео від фахівців ХЛР, де наочно показано, як зручно й просто проводити дослідження з Compact Dry:
Існує 16 видів унікальних сухих поживних середовищ для контролю гігієни й патогенних мікроорганізмів:
| Ідентифікатор | Вид мікроорганізмів |
| TC | Загальне мікробне число |
| TCR | Швидкий тест «Загальне мікробне число» |
| EC | Escherichia coli и Coliform |
| CF | Coliform |
| ETB | Enterobacteriaceae |
| ETC | Enterococci |
| SL | Salmonella |
| X-SA | Staphylococcus aureus |
| LS | Listeria spp. |
| LM | L. monocytogenes |
| VP | Vibrio parahaemolyticus |
| X-BC | Bacillus cereus |
| YM | Дріжджі та пліснява |
| YMR | Швидкий тест «Дріжджі та пліснява» |
| AQ | Heterotrophic water bacteria |
| PA | Pseudomonas |
Як працювати з Compact Dry
Усе дуже просто! Ви робите пробопідготовку самого зразка чи берете змив. Після цього ставите зразок на підкладку. Далі інкубуєте і зчитуєте результат.
Також Compact Dry Ви можете використовувати для методу мембранної фільтрації. Щоби було простіше брати змив із поверхні, для цього методу передбачено окремі сваби з 1 мл буферу.
- Дістаєте сваб, берете зону змиву 10 х 10
- Ставите назад у пристрій, закручуєте
- Відбувається контамінація – змішування вмісту тампона з буфером
- Після цього відкручуєте нижню частину, виливаєте все у підкладку Compact Dry і поміщаєте в інкубатор
- Завершальний крок – інтерпретація результату
Підсумуємо. Compact Dry – це:
- 16 видів унікальних сухих поживних середовищ для контролю гігієни й патогенних мікроорганізмів
- Яскравий колір колоній завдяки хромогенним субстратам
- Сертифікати від MicroVAl, NordVal та АОАС
- Маленькі й компактні, стерилізовані, готові до використання
- Термін зберігання до 2 років за кімнатної температури – холодильник не потрібен!
- Пластини легко укладаються в стопку і мають безпечну закриту кришку
З будь-якими запитаннями щодо методу або щодо продукції Compact Dry – звертайтеся до фахівця ХЛР.


